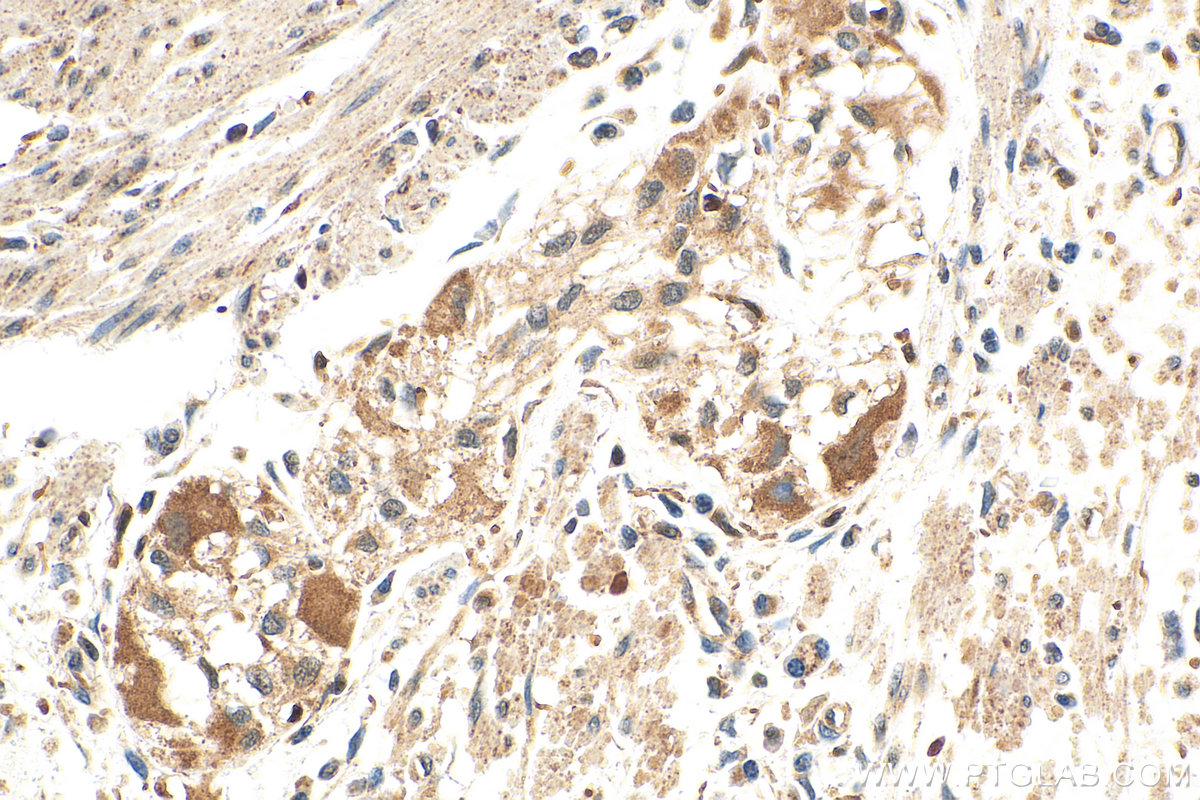

验证数据展示
产品信息
67029-1-PBS targets LSM12 in WB, IHC, FC (Intra), Indirect ELISA applications and shows reactivity with human, mouse, rat samples.
| 经测试应用 | WB, IHC, FC (Intra), Indirect ELISA Application Description |
| 经测试反应性 | human, mouse, rat |
| 免疫原 |
CatNo: Ag28782 Product name: Recombinant human LSM12 protein Source: e coli.-derived, PET28a Tag: 6*His Domain: 1-195 aa of BC044587 Sequence: MAAPPGEYFSVGSQVSCRTCQEQRLQGEVVAFDYQSKMLALKCPSSSGKPNHADILLINLQYVSEVEIINDRTETPRPLASLNVSKLASKARTEKEEKLSQAYAISAGVSLEGQQLFQTIHKTIKDCKWQEKNIVVMEEVVITPPYQVENCKGKEGSALSHVRKIVEKHFRDVESQKILQRSQAQQPQKEAALSS 种属同源性预测 |
| 宿主/亚型 | Mouse / IgG2a |
| 抗体类别 | Monoclonal |
| 产品类型 | Antibody |
| 全称 | LSM12 homolog (S. cerevisiae) |
| 别名 | 2E3G3, Protein LSM12 |
| 观测分子量 | 22 kDa |
| GenBank蛋白编号 | BC044587 |
| 基因名称 | LSM12 |
| Gene ID (NCBI) | 124801 |
| RRID | AB_2882344 |
| 偶联类型 | Unconjugated |
| 形式 | Liquid |
| 纯化方式 | Protein A purification |
| UNIPROT ID | Q3MHD2 |
| 储存缓冲液 | PBS only, pH 7.3. |
| 储存条件 | Store at -80°C. The product is shipped with ice packs. Upon receipt, store it immediately at -80°C |